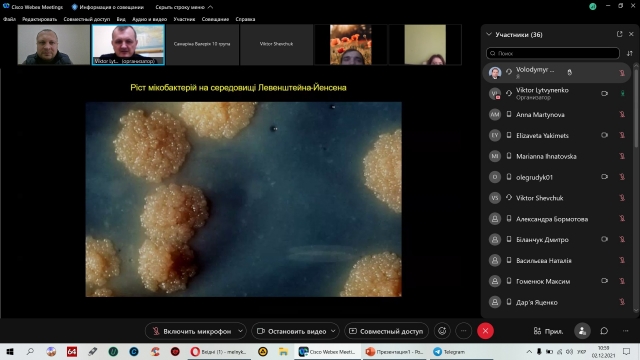

Відкрита лекція з дисципліни «Епізоотологія та інфекційні хвороби» у студентів 3 курсу
В другий день зими на кафедрі Епізоотології, мікробіології і вірусології доцентом Віктором Шевчуком було прочитано відкриту лекцію для студентів 3 курсу, які навчаються за скороченою програмою спеціальності «Ветеринарна медицина» ОС «Бакалавр». Тема ж лекції – «Туберкульоз», актуальна, адже в Україні з 1995 року оголошено епідемію даної хвороби, яка триває до сьогодні.

Відвідали лекцію не тільки студенти 9 і 10 груп, які здивували майже стовідсотковою присутністю, але й колеги по кафедрі.

Розпочав заняття Віктор Миколайович із визначення хвороби та історії її вивчення. Адже захворювання було відоме людству з давніх-давен і багато вчених усього світу взяло участь у вивченні туберкульозу. Першовідкривачем збудника туберкульозу є німецький вчений Роберт Кох, який 24 березня 1882 року повідомив про свої здобутки на засіданні Берлінського товариства фізіологів. З того часу 24 березня відмічається в усьому світі як День боротьби з туберкульозом.

А далі інформація про захворювання «посипалась рікою …»

Студенти побачили як виглядає збудник туберкульозу в електронному мікроскопі, а також як ростуть колонії мікобактерій на живильному середовищі.

Особливу увагу Віктор Шевчук зосередив на інформації щодо зажиттєвої та посмертної діагностики хвороби у сільськогосподарських тварин із застосування різних методів, оскільки лікування хворих на туберкульоз тварин не проводиться і ефективних вакцин для тваринництва, на жаль, не розроблено.

Загалом лекція була змістовною, цікавою не тільки для студентів, а також і для викладачів кафедри.
Володимир Мельник, завідувач кафедри епізоотології, мікробіології і вірусології
